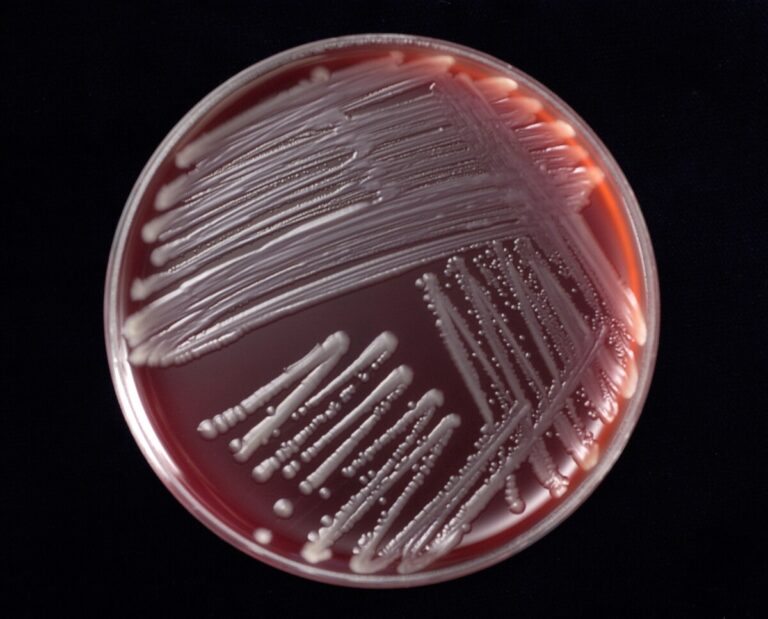

Trots förbättringar – antibiotikaresistens fortsatt hot
Förekomsten av antibiotikaresistens hos bakterier som orsakar livsmedelsburna infektioner som salmonella och campylobakter är fortsatt hög i Europa. Däremot har resistensläget bland tarmbakterier hos friska djur förbättrats i många länder. Men trots förbättringarna har många länder mycket kvar innan de uppnår samma stabila nivå som i Sverige, skriver SVA.
Den årliga rapporten från ECDC, den europeiska smittskyddsmyndigheten, och EFSA, den europeiska livsmedelssäkerhetsmyndigheten, publicerade nyligen resultaten från övervakningen av antibiotikaresistens från åren 2018 och 2019. Den visar att läget fortsätter att förbättras på flera håll i Europa. Till exempel är det ytterligare några länder där en ökande andel av slumpmässigt utvalda tarmbakterier av typen E. coli från friska djur är känsliga för alla undersökta antibiotika.
–Användningen av antibiotika till djur har i många länder minskat de senaste åren och troligen är detta vad som nu ger utdelning i form av lägre förekomsts av resistenta bakterier, säger Oskar Nilsson, veterinär och antibiotikaexpert SVA.
Trots att resistensläget förbättrats i flera länder är det fortfarande stora skillnader inom Europa. Vissa länder har en bra situation jämfört med andra länder, och där är Sverige en av de bättre. Ett exempel är att omkring 70 procent av slumpmässigt utvalda tarmbakterier av typen E. coli från friska djur i Sverige är känsliga för alla undersökta antibiotika medan andelen är under 40 procent i majoriteten av länderna i Europa.
– I Sverige har vi länge arbetat under parollen ”friska djur behöver inte antibiotika”. Det långsiktiga och målmedvetna arbetet med att hålla djuren friska minskar behovet att behandla djur. Detta, tillsammans med en klok antibiotikaanvändning när det verkligen behövs, har gjort att läget bland djur i Sverige är fördelaktigt, säger Oskar Nilsson.
Källa: SVA Bilden föreställer en blodagarplatta med E. colibakterier. Foto: SVA






















